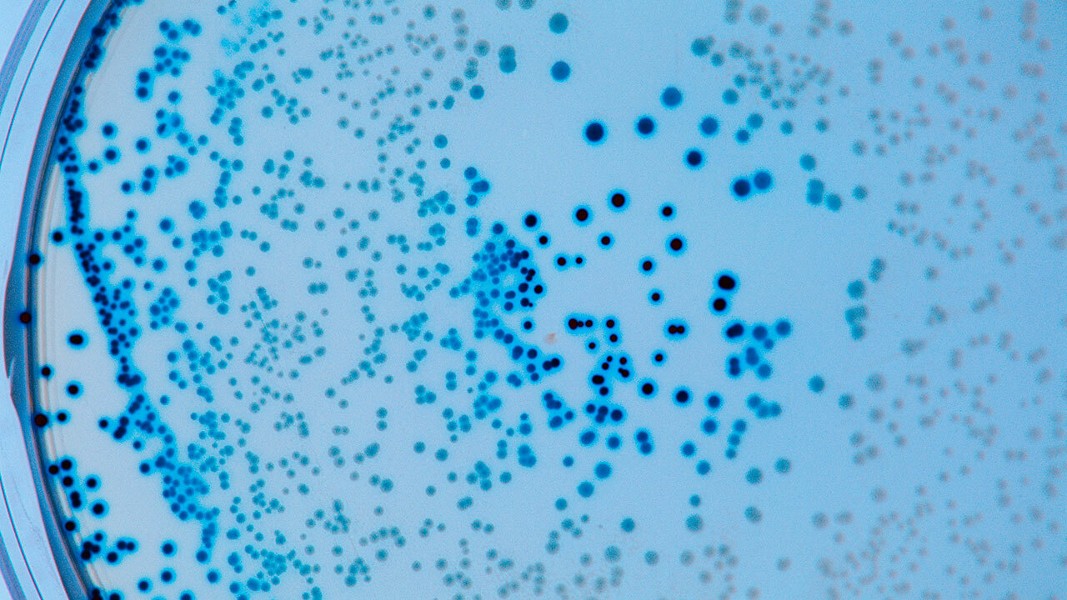

A (Monkey)Pox on Both Their Houses: Two Outbreaks and Two Administrations Later, the U.S. Remains Unprepared for Public Health Emergencies
The following article is republished with permission from the Premier, Inc. weblog.
Americans have been living with COVID-19 for nearly three years. At its onset, COVID-19 was novel, with no known treatments, vaccines or prevention protocols in place, enabling a rapid spread that quickly overran the U.S. population and exposed many weaknesses inherent in our public health system.
Flash forward to today, where the nation’s latest public health emergency (PHE) concerns monkeypox.
Considering the U.S. just emerged battle hardened from a global pandemic, it is natural to assume we are well prepared to respond, particularly to a monkeypox virus that is well known, with existing treatments and vaccines.
While we’ve made some progress, unfortunately, it appears we still have work to do.
In a re-run of the errors exposed during the early COVID-19 response, monkeypox tests and vaccines have been difficult to obtain, surveillance has been spotty and public health agencies continue to lack communication and coordination, making it challenging to get ahead of disease spread.
In this blog, we examine the technology, data, supply chain and coordination weaknesses exposed by COVID-19, and rate whether we are better prepared to manage these realities for monkeypox.
Little to no syndromic surveillance to predict community outbreaks.
Did We Fix It? Red light
 In the early days of the pandemic, Premier leveraged PINC AI™ clinical decision support to scan free text within ambulatory medical records, searching for symptoms that could predict a potential COVID-19 outbreak. Using this solution, we were able to effectively predict surges and regional flare ups well before patients started showing up at the hospital for treatment.
In the early days of the pandemic, Premier leveraged PINC AI™ clinical decision support to scan free text within ambulatory medical records, searching for symptoms that could predict a potential COVID-19 outbreak. Using this solution, we were able to effectively predict surges and regional flare ups well before patients started showing up at the hospital for treatment.
Armed with positive results, Premier became a steadfast advocate for federal agencies, such as the Centers for Disease Control and Prevention (CDC), to adopt a national system for syndromic surveillance. With a technology-enabled overlay monitoring for symptom clusters, we argued the nation would be better able to track and predict outbreaks – and quicken response times.
Congress and the prior administration agreed, giving the CDC $500 million[i] to improve its data surveillance programs.
Despite recognizing the need and cash infusion, the CDC noted that in late July it only has current data on half of the nation’s reported monkeypox cases[ii]. Even today, the CDC only has data on those with a monkeypox diagnosis, and no data on early warning symptoms – meaning it can see outbreak epicenters that exist but cannot proactively predict them in advance.
Battling disease without predictive data is the equivalent of fighting with one hand tied behind the back. There remains an urgent, unaddressed need to improve surveillance to monitor not just for caseloads, but for all symptoms that could indicate a potential outbreak. Although monkeypox today only leads to hospitalizations in 5-7 percent of all cases, we need to be sure we keep those numbers low with proactive intervention and treatment.
A lack of data and transparency around supply availability and allocation methods.
Did We Fix It? Yellow light
 Providers need both clinical surveillance and supply chain data to provide high-quality patient care. Yet a major barrier to the COVID-19 response was the lack of information on the exact quantities and locations of medical supplies and drugs on U.S. soil at any given time. Our nation’s limited information on the location, production process and inventory status amounted to a supply chain guessing game to find products and earmark them based on patient need. It can also be argued that as states bid against other states, and providers bid against other providers – this all led to a rapid escalation in supply costs, which we are still seeing today.
Providers need both clinical surveillance and supply chain data to provide high-quality patient care. Yet a major barrier to the COVID-19 response was the lack of information on the exact quantities and locations of medical supplies and drugs on U.S. soil at any given time. Our nation’s limited information on the location, production process and inventory status amounted to a supply chain guessing game to find products and earmark them based on patient need. It can also be argued that as states bid against other states, and providers bid against other providers – this all led to a rapid escalation in supply costs, which we are still seeing today.
We continue to lack information on supplies needed to provide COVID-19 and monkeypox treatment, all with the 2022 flu season on the horizon, already predicted as monumental based on data from the Southern Hemisphere (and unknowns about the impacts of a polio reemergence). Adding to this are continued bottlenecks at U.S. ports and potential supply limits on petroleum-based goods (i.e., anything made with a plastic resin) due to the war in Ukraine. Constraints on natural gas from geopolitical issues in Ukraine also threaten the manufacturing of vaccines.
It’s well past time we modernize the U.S. supply chain data infrastructure for the 21st century – one the nation can summon on-call to help manage a large-scale emergency.
During COVID-19, for instance, providers and government agencies turned to Premier’s real-time technology system to gain visibility into hospital inventory, including stockpiles, providing visibility to the NDC and SKU level. Armed with data, entities in both the public and private sectors could see where products were stocked as well as any gaps in resources.
But this progressive monitoring approach needs to extend across our nation’s supply chain – allowing for advanced alerts of demand signaling and inventory levels, and the dynamic allocation of product to areas of greatest need.
The bipartisan Medical and Health Stockpile Accountability Act introduced in the House would enable – for the first time – real-time data on the entire supply chain for critical medical supplies needed to treat patients during emergencies. The bill contains many of Premier’s recommendations, and we encourage its expeditious passage.
A cumbersome, manual process for tracking and reporting the spread of disease.
Did We Fix It? Yellow light
 During COVID-19, virtually all reporting was done using paper-based forms that were then faxed back to the state and local public health departments for recording and follow up. Reporting was limited to hospitals providing treatment for the most severe cases and labs that encountered a positive COVID-19 test. Forms, cumbersome and time-consuming to complete, coupled with limits on the providers required to report, meant public health agencies received no information from milder cases diagnosed in a physician office, or from patients self-diagnosed via at-home tests.
During COVID-19, virtually all reporting was done using paper-based forms that were then faxed back to the state and local public health departments for recording and follow up. Reporting was limited to hospitals providing treatment for the most severe cases and labs that encountered a positive COVID-19 test. Forms, cumbersome and time-consuming to complete, coupled with limits on the providers required to report, meant public health agencies received no information from milder cases diagnosed in a physician office, or from patients self-diagnosed via at-home tests.
Fast forward to monkeypox and some improvements in reporting can be found. Any labs performing a monkeypox test are now required to report all results directly to public health departments, which should capture all confirmed cases. Moreover, labs are strongly encouraged to submit this data electronically, as opposed to via paper forms.
However, electronic reporting is still not a requirement and public health case investigation forms (used to track the source of transmission) are still paper based – and more than six pages long!
Inadequate testing strategy.
Did We Fix It? Yellow light
 The myriad of problems associated with COVID-19 testing were well documented. Starting with a lack of testing locations, followed by a shortage of specimen collection swabs, inadequate lab capacity to process tests and sporadic genomic sequencing to monitor for variants, the COVID-19 testing model saw major issues.
The myriad of problems associated with COVID-19 testing were well documented. Starting with a lack of testing locations, followed by a shortage of specimen collection swabs, inadequate lab capacity to process tests and sporadic genomic sequencing to monitor for variants, the COVID-19 testing model saw major issues.
With monkeypox, efforts to speed access to testing have been far swifter than it was during the pandemic. For instance, in California, public health officials were still restricting access to COVID-19 testing facilities six months into the outbreak. This year, the CDC effectively onboarded commercial labs to expand testing for monkeypox within one month. While an improvement, that one month delay has had consequences. With only about 70 labs authorized to conduct testing in the spring, bottlenecks were widespread.[iii]This is why from mid-May to the end of June, the U.S. had run tests on just 2,500 samples[iv], despite ample evidence suggesting a large-scale outbreak. Limited capacity has also meant that screening for potential variants has also been lacking, which could open the door to future, more severe threats.
Moreover, the only test the U.S. Food and Drug Administration (FDA) has approved requires swabbing the lesions associated with monkeypox – a later-stage symptom. The declaration of the PHE should help, as it will enable the FDA to leverage emergency use authorizations to approve other tests that may help with earlier diagnosis, but by the time that authority is invoked, a full-scale outbreak may be underway.
In addition, testing takes entirely too long. Currently, labs can only test for orthopoxvirus, the family of viruses that include monkeypox. Any positive samples are then sent to the CDC for more refined testing. This two-step process means that many are waiting up to four+ days for results, time when infected individuals can continue to get sicker and spread the virus to more individuals. As we learned during COVID-19, delays of even a day can have dire effects on limiting transmission.
A clunky mass vaccination strategy.
Did We Fix It? Red light
 Controlling the growing monkeypox outbreak not only relies on an effective testing approach, but also the availability of millions of vaccine doses. Currently, the U.S. monkeypox vaccination campaign has faced major hurdles as demand for shots is exceeding supply – leading to long lines at clinics and even protests in some cities.
Controlling the growing monkeypox outbreak not only relies on an effective testing approach, but also the availability of millions of vaccine doses. Currently, the U.S. monkeypox vaccination campaign has faced major hurdles as demand for shots is exceeding supply – leading to long lines at clinics and even protests in some cities.
When monkeypox was first detected in the U.S. in May, the administration announced that the nation had enough smallpox vaccine (also approved for monkeypox) in the Strategic National Stockpile (SNS) “to deal with the likelihood of a problem.” But by the end of July, for instance, New York public health agencies had access to only about half the vaccines[v] needed to curb what once again appears to be the epicenter of a major outbreak. Meanwhile, California lawmakers are calling their allocation of vaccines a “drop in the bucket.”[vi]
The problem rests with the fact that many of the stockpiled doses consisted of the older ACAM2000® vaccine, which can carry significant risk, especially for those with compromised immune systems. The alternative vaccine – Jynneos™ – carries fewer risks, but the SNS only held 2,400 doses[vii] at the outbreak’s onset.
Since then, officials have been scrambling to secure doses and prioritize monkeypox vaccination. With lower stock and limited capacity to quickly produce more products, public health officials have now introduced a dose-sparing strategy[viii] to stretch limited supply, which some infectious disease experts are calling into question given unknowns around risk to vaccine effectiveness. Preliminary data on monkeypox vaccination will be forthcoming, and it’s vital that our public health vaccination approach is grounded in science – not based on a lack of planning or preparedness.
Limited supplies also restrict access, with vaccines only being distributed to designated health centers and clinics – not to primary care providers or local pharmacies that have the broadest reach into the community.
The good news is monkeypox vaccine availability will increase in the months ahead, but given concerns around transmissibility, disease spread and the potential for new variants these efforts may be too little, too late. There are increasing calls to invoke the Defense Production Act to help increase supply and enable quicker access to monkeypox vaccines – a strategy the administration could and should consider. And as supply improves, equally important is vaccine education to help overcome hesitancy and improve monkeypox vaccination rates.
Poor infrastructure surrounding the Strategic National Stockpile (SNS).
Did We Fix It? Yellow light
 A Premier member survey from October 2020 found that many health systems considered stockpiles to be an important preparation strategy. However, as demonstrated by COVID-19 and now monkeypox, a fragmented approach to securing supplies creates confusion and competition that can contribute to shortages.
A Premier member survey from October 2020 found that many health systems considered stockpiles to be an important preparation strategy. However, as demonstrated by COVID-19 and now monkeypox, a fragmented approach to securing supplies creates confusion and competition that can contribute to shortages.
Today, it’s positive progress that we’re seeing greater transparency into the quantities of products and supplies available through the SNS, including available doses of the monkeypox vaccine. However, the U.S. still lacks a cohesive national stockpiling strategy, and providers remain bogged down with a cumbersome, paper-based process to request SNS supplies. This includes procuring Tpoxx, the only “investigational” drug available to treat monkeypox, which currently requires physicians already struggling with burnout and labor challenges to complete a 27-page application[ix] or provide detailed patient information to procure.
The result? The distribution process for existing SNS supplies during the monkeypox outbreak has not been as clear and smooth as it could have been.
Premier believes the SNS must be built by providers for providers. For example, had providers had a seat at the table in helping to determine the contents of the SNS, doses of the older ACAM vaccine may have been switched out for the newer Jynneos vaccine, leading to greater supply availability. The SNS must also leverage data and insights to assist providers in the delivery of care during global pandemics that is in the best interest of patients – and to ensure access to the right supplies, at the right time.
Premier continues to advocate for the creation of a national standard that integrates stockpiling needs at the federal, state and health system levels.
An overreliance on overseas manufacturing for many critical goods.
Did We Fix It? Yellow light
 COVID-19 was the wakeup call that rang the alarm bell on issues with the globalization, overseas overreliance and fragility of our supply chains.
COVID-19 was the wakeup call that rang the alarm bell on issues with the globalization, overseas overreliance and fragility of our supply chains.
Fortunately, many U.S. lawmakers and private sector actors did hear the alarm, taking steps to bring greater diversity to the market.
Within the private sector, healthcare providers are leading the way to change how we source critical medical supplies and drugs. Hundreds of Premier member health systems have stepped up to incent U.S. manufacturers, including Prestige Ameritech for N95 respirators and face masks, DeRoyal Industries for isolation gowns, Honeywell for nitrile exam gloves and Exela Pharma Sciences for pharmaceuticals, including some critical shortage drugs. Notably, these efforts prioritize collaborations that leverage existing production capacity, providing a more sustainable approach to U.S.-based production rather than building from the ground up.
In Washington, D.C., supply chain resiliency was advanced when the bipartisan CHIPS and Science Act of 2022[x] signed into law. The legislation aims to boost U.S.-based manufacturing of semiconductors – a vital component in nearly every device we use today, including healthcare devices – to help mitigate future supply chain challenges and increase competition with China.
While these actions represent important and meaningful progress, scaling domestic and diverse manufacturing isn’t going to come easy. It will require a continued and massive effort on behalf of the U.S. manufacturing industry and the federal government to generate the necessary public policy support (i.e., tax incentives and other affordable financing options for U.S. manufacturers) to truly compete in the cost-competitive global marketplace.
While global challenges persist, there do not appear to be any widespread supply shortages associated with monkeypox treatment needs – at least not today. But the supply chain remains fragile and must be continually monitored to ensure the free flow of healthcare goods.
Coordination among the various government agencies leading the response efforts.
Did We Fix It? Yellow light
 With the national response to COVID-19 in early 2020, the array of responding federal agencies had little insight into what their counterparts were doing, leading to overlaps, conflicts and duplication. At the same time, there was confusion among the states, which had little guidance as to what they were responsible for, how to coordinate with federal teams or how they should organize their own mitigation efforts.
With the national response to COVID-19 in early 2020, the array of responding federal agencies had little insight into what their counterparts were doing, leading to overlaps, conflicts and duplication. At the same time, there was confusion among the states, which had little guidance as to what they were responsible for, how to coordinate with federal teams or how they should organize their own mitigation efforts.
With monkeypox, the Administration for Strategic Preparedness and Response (ASPR) has been named as national coordinator of the response effort, and we did move swiftly to declare a PHE needed for regulatory flexibility. However, ASPR’s new authorities are developing in real time, and individuals from the Federal Emergency Management Agency and CDC have been named as directors of the response efforts, again raising questions about oversight and management.
Meanwhile, state public health agencies on the frontlines continue to struggle with access to tests, treatments, vaccines and – most important – funding. For many public health agencies, response funding is categorical, and moving money from one disease to another (like from COVID-19 to monkeypox) requires both state and federal approval. These added layers of red tape limit the ability to implement continuous disease prevention systems and undermine rapid response. In California, for instance, there are 78 different public health funding streams, all earmarked for specific disease states and all of which much be separately tracked[xi]. This means that the COVID-19 budget at this point is probably bloated, while the monkeypox response is lacking.
Collaboration between the public and private sectors.
Did We Fix It? Green light
 From the early days of COVID-19 and through today, the public and private sectors have come together in unprecedented ways to tackle these “once in a century,” pandemic-driven challenges.
From the early days of COVID-19 and through today, the public and private sectors have come together in unprecedented ways to tackle these “once in a century,” pandemic-driven challenges.
COVID-19 vaccines and treatments were developed and distributed in record time, and even amid ongoing case spikes, are proving effective in keeping people out of the hospital and saving countless lives – demonstrating the awesome power of science and ingenuity.
Research and the practice of medicine have also been driven forward. Just during the pandemic, Premier captured more than 5M COVID+ patient encounters – fueling leading research in 47 publications from the CDC, National Institutes of Health and other public sector organizations that are helping to improve the quality, safety and cost-effectiveness of patient care. Even now, we are starting to collect data on monkeypox and should be able to support future-focused research for this outbreak as well.
Vital public-private sector collaboration is also building a more sustainable and robust healthcare supply chain – helping to ensure that providers have access to the critical products and supplies necessary to protect their frontline workers and treat patients.
Early in the pandemic, the Private Sector Supply Chain Coalition comprised of group purchasing organizations, distributors, manufacturers and others – provided information and invaluable data on inventory levels for providers, locations of supplies and areas of heightened demand. Today, Premier continues to work closely with White House leadership and other federal agencies to help manage the nation’s supply chain issues and serves as the only group purchasing organization invited to participate in the Administration’s Healthcare and Public Health (HPH) Sector Joint Supply Chain Resilience Working Group – supporting strategies to gather data, forecast demand and increase available supplies.
Continued information-sharing and collaboration will help ensure a path to a more agile and robust response to PHEs jointly established by the federal government and industry partners – for monkeypox and beyond.
The End Result
While we’ve learned some vital lessons from the COVID-19 pandemic, monkeypox exposed the fact that many challenges remain. The U.S. is slower to identify public health threats and lacks ability to think ahead about potential logistics issues associated with specific outbreaks. Data and technology need scale, and we need to streamline cumbersome processes that limit providers and public health officials.
The bright side? Together, we can initiate the real reforms that are required for an agile response to emergencies. And Premier believes we will.
In and out of a pandemic, Premier continues to work in close collaboration with healthcare providers, manufacturers, distributors and government organizations to help ensure access to the supplies, data and intelligence needed now and for the future.






